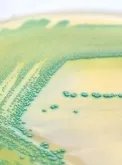
绿瘦瘦身组合(纤丽宝牌玉人胶囊)

绿瘦瘦身组合(纤丽宝牌玉人胶囊)
的有关信息介绍如下:1、产品名称:绿瘦瘦身组合(纤丽宝牌玉人胶囊)
产品简介:
绿瘦瘦身组合是由薏苡仁、荷叶、等多种药、食同源绿色植物,采用活性萃取技术,天然的功效成分,独有的植物膳食纤维,为您打造全天然、健康、安全无副作用的瘦身配方。
在(清脂、清肠、清血)三清的基础上,彻底达到瘦腰、瘦腹、瘦臀、瘦腿的四维瘦身目的,全面清除脂肪,同时全面调节脾胃、肠、肝胆、肺肾等五脏六腑,益气降火、活血化淤、排毒管道畅通,使体内脂肪迅速转化,让营养均衡吸收,植物膳食纤维的独特功能,使皮肤细嫩、光滑、白皙,身材自然更加完美无缺。
2、产品功效:
95%用户排出毒素,肠胃明显改善
身体在得到良好的调解之后,每天定量排出身体中的毒素。当吸收和排泄呈现正常,身体就会呈现一种平衡的状态。
80%用户体型得到改善,获得迷人曲线
含有大量的植物膳食纤维,减肥后能保持皮肤紧致,刺激弹性纤维生长,恢复原有的弹性,塑造完美曲线。
3、产品优点:
健康摄取天然植物成分,易于溶解和吸收!
安全 不含任何激素成分,无任何副作用!
轻松 无需运动、无需节食,无需压制食欲!
定向:
只减脂肪,不减胸部 保证完美身段!
(责任编辑:杨淼)



